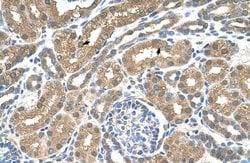
Invitrogen SLC16A8 Polyclonal Antibody 100 &mu;L; Unconjugated:Antibodies,

missing translation for 'onlineSavingsMsg'
Learn More
Learn More
Invitrogen™ SLC16A8 Polyclonal Antibody


Rabbit Polyclonal Antibody
Brand: Invitrogen™ PA542458
Denne vare kan ikke returneres.
Se returpolicy
Beskrivelse
Peptide sequence: RAFAVYAVTK FLMALGLFVP AILLVNYAKD AGVPDTDAAF LLSIVGFVDI Sequence homology: Cow: 86%; Dog: 92%; Guinea Pig: 100%; Horse: 86%; Human: 100%; Mouse: 86%; Rabbit: 86%; Rat: 93%; Zebrafish: 79%.
SLC16A8 is proton-linked monocarboxylate transporter. It catalyzes the rapid transport across the plasma membrane of many monocarboxylates such as lactate, pyruvate, branched-chain oxo acids derived from leucine, valine and isoleucine, and the ketone bodies acetoacetate, beta-hydroxybutyrate and acetate.
Tekniske data
| SLC16A8 | |
| Polyclonal | |
| Unconjugated | |
| SLC16A8 | |
| LOW QUALITY PROTEIN: monocarboxylate transporter 3; MCT 3; MCT3; monocarboxylate transporter; monocarboxylate transporter 3; monocarboxylate transporter 3; LOW QUALITY PROTEIN: monocarboxylate transporter 3; preferentially expressed in RPE cells and choroid plexus epithelium; proton-coupled monocarboxylate transporter 3; REMP; Slc16a8; solute carrier 16 (monocarboxylic acid transporters), member 8; solute carrier family 16 (monocarboxylate transporter), member 8; solute carrier family 16 (monocarboxylic acid transporters), member 8; solute carrier family 16 member 8; solute carrier family 16, member 8 (monocarboxylic acid transporter 3) | |
| Rabbit | |
| Protein A | |
| RUO | |
| 23539 | |
| -20°C, Avoid Freeze/Thaw Cycles | |
| Liquid |
| Immunohistochemistry, Western Blot | |
| 1 mg/mL | |
| PBS with 2% sucrose and 0.09% sodium azide | |
| O95907 | |
| SLC16A8 | |
| Synthetic peptide directed towards the middle region of human SLC16A8. | |
| 100 μL | |
| Primary | |
| Human | |
| Antibody | |
| IgG |
Korrektion af produktindhold
Dit input er vigtigt for os. Udfyld denne formular for at give feedback relateret til indholdet på dette produkt.
Produkttitel
Ser du en mulighed for forbedring?Del en indholdskorrektion